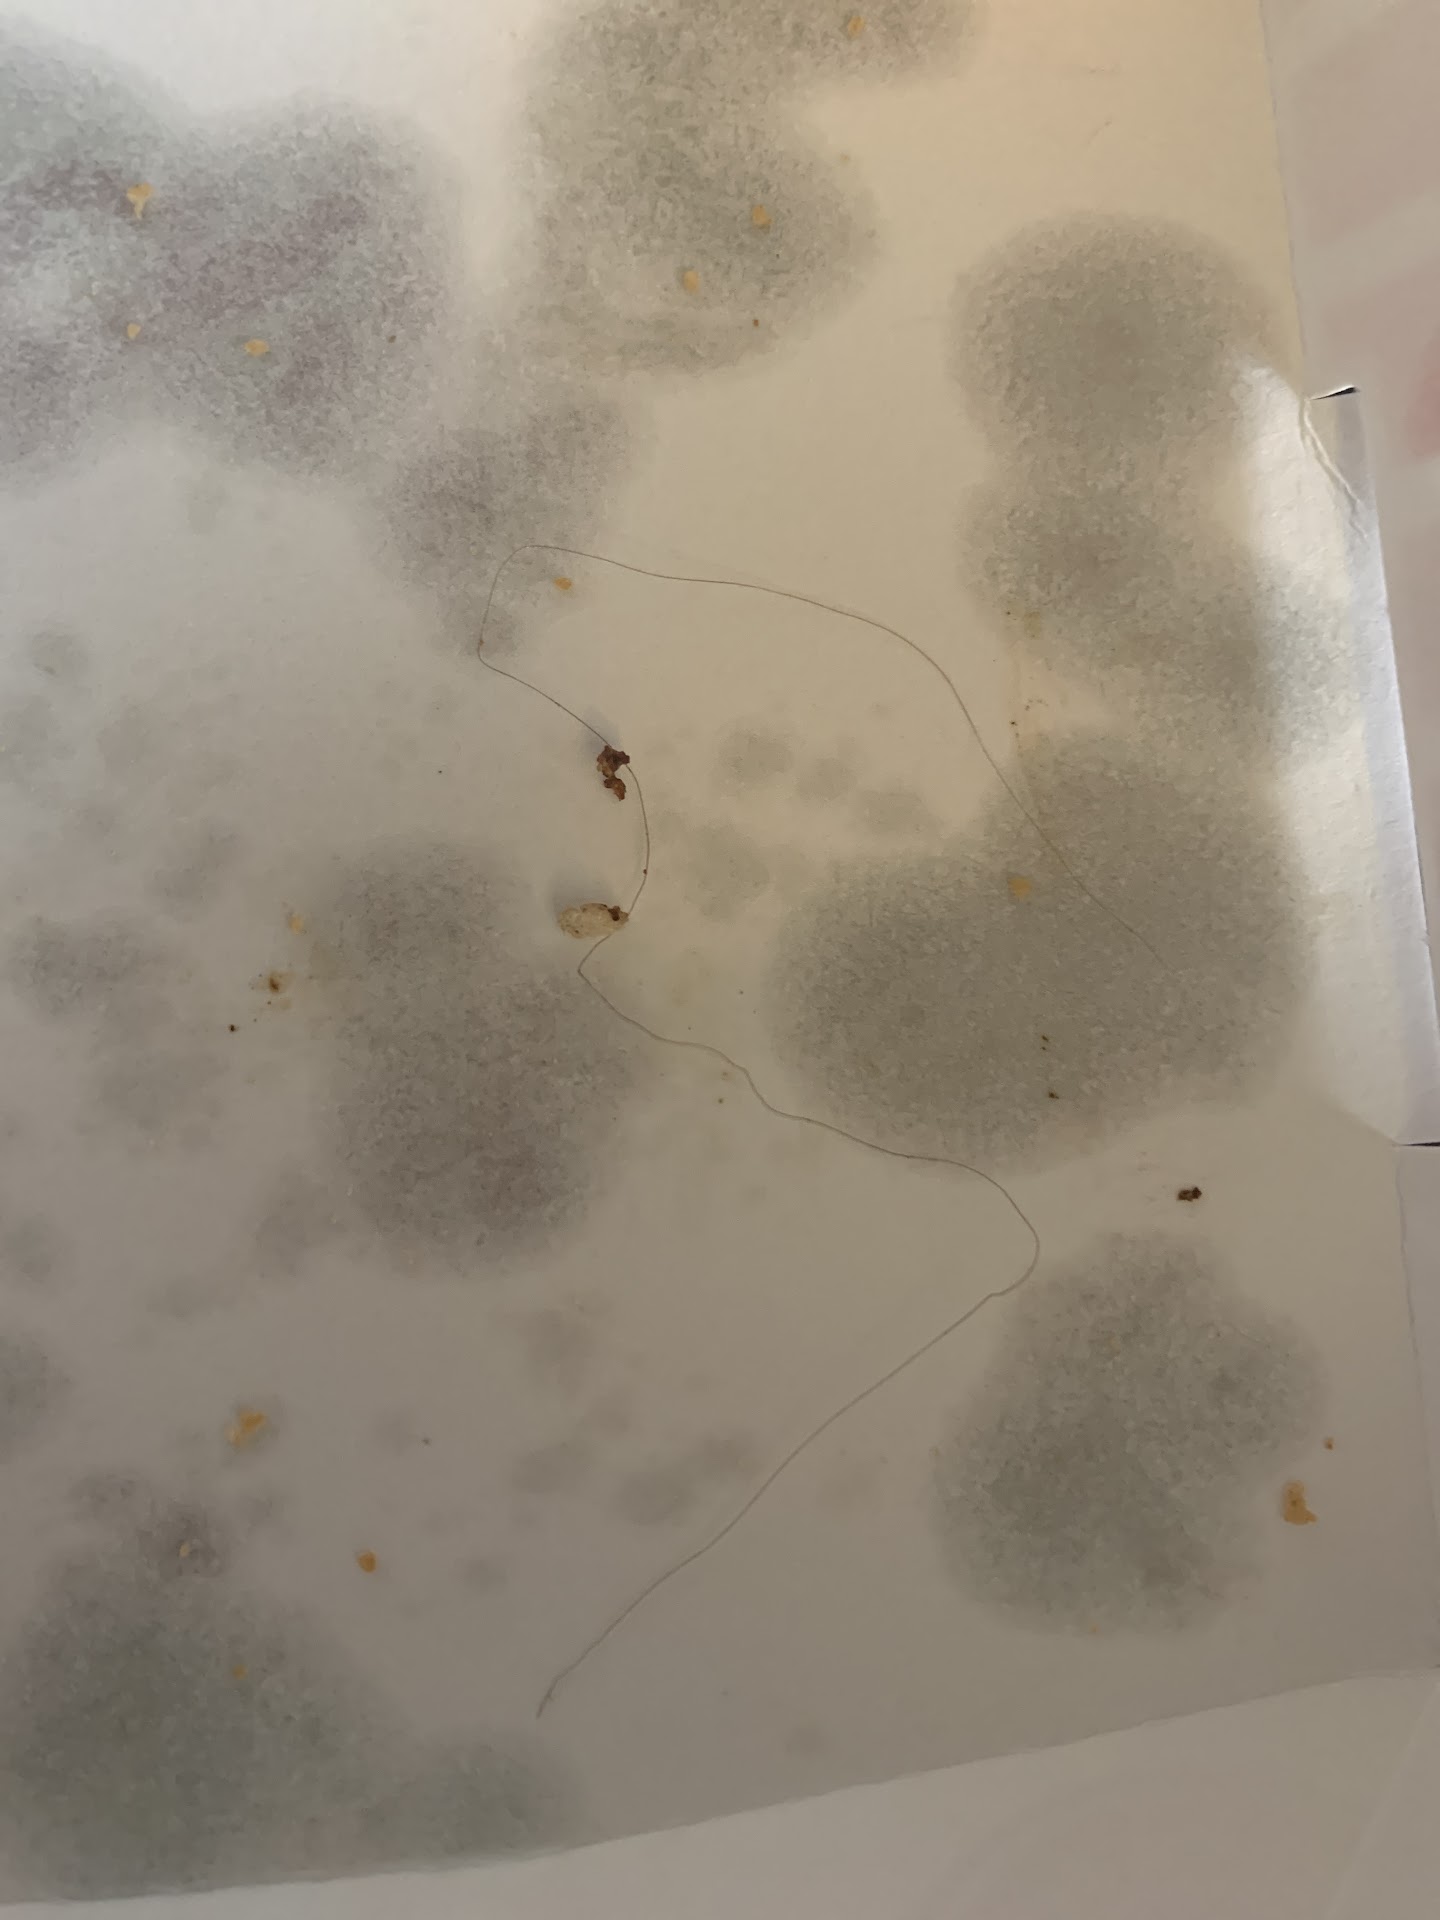
See more posts

Freddy's Frozen Custard & Steakburgers things to do, attractions, restaurants, events info and trip planning

Basic Info
Freddy's Frozen Custard & Steakburgers
7010 W Hefner Rd, Oklahoma City, OK 73162
4.1(519)$$$$
Open until 10:00 PM



delivery
Save
spot
spot
Ratings & Description
Info
Vintage-style chain for steakburgers, hot dogs & other fast-food staples, plus frozen custard.
attractions: , restaurants: Henry Hudson's Grill, Chuanyu Fusion 川渝食府, Braum's Ice Cream & Dairy Store, Babble Coffee & Boba Tea Bar, Fresh Donuts, Taco Bell, Jimmy's Egg, Mazzio’s Pizza & Wings, Haydeh's Bistro, Speedy Wok, local businesses: Golden Nails & Spa | Best Nail Salon In Oklahoma 73162, Crest Foods, RadioActive Threads, Master Phone Repair
 Learn more insights from Wanderboat AI.
Learn more insights from Wanderboat AI.Phone
(405) 728-4354
Website
freddys.com
Open hoursSee all hours
Tue10:30 AM - 10 PMOpen
Plan your stay

Pet-friendly Hotels in Oklahoma City
Find a cozy hotel nearby and make it a full experience.

Affordable Hotels in Oklahoma City
Find a cozy hotel nearby and make it a full experience.

The Coolest Hotels You Haven't Heard Of (Yet)
Find a cozy hotel nearby and make it a full experience.

Trending Stays Worth the Hype in Oklahoma City
Find a cozy hotel nearby and make it a full experience.
Featured dishes
View full menu

Kid's Tender Combo

Kid's Hot Dog Combo

Kid's Steakburger With Cheese Combo

BBQ Brisket Steakburger

Jalapeño Pepper Jack Double

Triple Steakburger

Grilled Cheese Steakburger

Crispy Chicken Club Sandwich

Grilled Chicken Club Sandwich

Freddy's Original Patty Melt

Freddy's Original Bacon And Cheese Double

California Style Double

Single Steakburger

Prime Rib Steakburger

Spicy Chicken Sandwich

3 Piece Chicken Tender

Smoky Bacon Cheddar Stack Steakburger

Freddy's Original Double

Veggie Burger

All-Beef Hot Dog

5 Piece Chicken Tender

Freddy's Famous Jalapeño Fry Sauce®

Freddy's Famous Steakburger & Fry Seasoning®

Freddy's Famous Fry Sauce®

Freddy's Smoky Fry Sauce®

Fountain Drink

Chocolate Milk

Apple Juice

Milk

Grilled Chicken Club Sandwich Combo

Single Steakburger Combo

Freddy's Original Double Combo

Prime Rib Steakburger Combo

Jalapeño Pepper Jack Double Combo

Spicy Chicken Sandwich Combo

3 Piece Chicken Tender Combo

Freddy's Original Patty Melt Combo

BBQ Brisket Steakburger Combo

Grilled Cheese Steakburger Combo

Veggie Burger Combo

Crispy Chicken Club Sandwich Combo

Smoky Bacon Cheddar Stack Combo

Triple Steakburger Combo

California Style Double Combo

5 Piece Chicken Tender Combo

All-Beef Hot Dog Combo

Freddy's Original Bacon And Cheese Double Combo

Tots

Freddy's Kettle Chips

Mott’s® Natural Applesauce

Cheese Fries

Freddy's Fries

Cheese Curds

Onion Rings

Reeses® Royale

Dirt 'N Worms

Strawberry Dreamcake

OREO® Custard Sandwich

Orange Cream Frost

Pints & Quarts

OREO® Double Trouble

MUG® Root Beer Float

Lemon Cream Frost

Cold Brew Caramel Crunch

Signature Turtle

Shakes

Dish (No Toppings)

Peanut Butter Bananza

Create Your Own

Chocolate Brownie Delight
Reviews
Live events

Trivia Night | Dave & Busters - Oklahoma City OKC - TUE 730p
Tue, Jan 27 • 7:30 PM
5501 North May Avenue, Oklahoma City, OK 73112
View details

Best in Grass Oklahoma Awards Show 2026
Wed, Jan 28 • 6:00 PM
2121 South Portland Avenue Oklahoma City, OK 73108
View details

Baby Bump + Brunch
Fri, Jan 30 • 11:00 AM
1621 South Douglas Boulevard #Unit C Midwest City, OK 73130
View details
Nearby restaurants of Freddy's Frozen Custard & Steakburgers
Henry Hudson's Grill
Chuanyu Fusion 川渝食府
Braum's Ice Cream & Dairy Store
Babble Coffee & Boba Tea Bar
Fresh Donuts
Taco Bell
Jimmy's Egg
Mazzio’s Pizza & Wings
Haydeh's Bistro
Speedy Wok

Henry Hudson's Grill
4.2
(209)
$
Open until 2:00 AM
Click for details

Chuanyu Fusion 川渝食府
4.5
(242)
$
Open until 12:00 AM
Click for details

Braum's Ice Cream & Dairy Store
4.2
(733)
$
Open until 10:45 PM
Click for details

Babble Coffee & Boba Tea Bar
4.7
(504)
$
Open until 8:00 PM
Click for details
Nearby local services of Freddy's Frozen Custard & Steakburgers
Golden Nails & Spa | Best Nail Salon In Oklahoma 73162
Crest Foods
RadioActive Threads
Master Phone Repair

Golden Nails & Spa | Best Nail Salon In Oklahoma 73162
4.8
(419)
Click for details

Crest Foods
4.4
(164)
Click for details

RadioActive Threads
5.0
(17)
Click for details

Master Phone Repair
4.0
(21)
Click for details
The hit list

Plan your trip with Wanderboat
Welcome to Wanderboat AI, your AI search for local Eats and Fun, designed to help you explore your city and the world with ease.
Powered by Wanderboat AI trip planner.